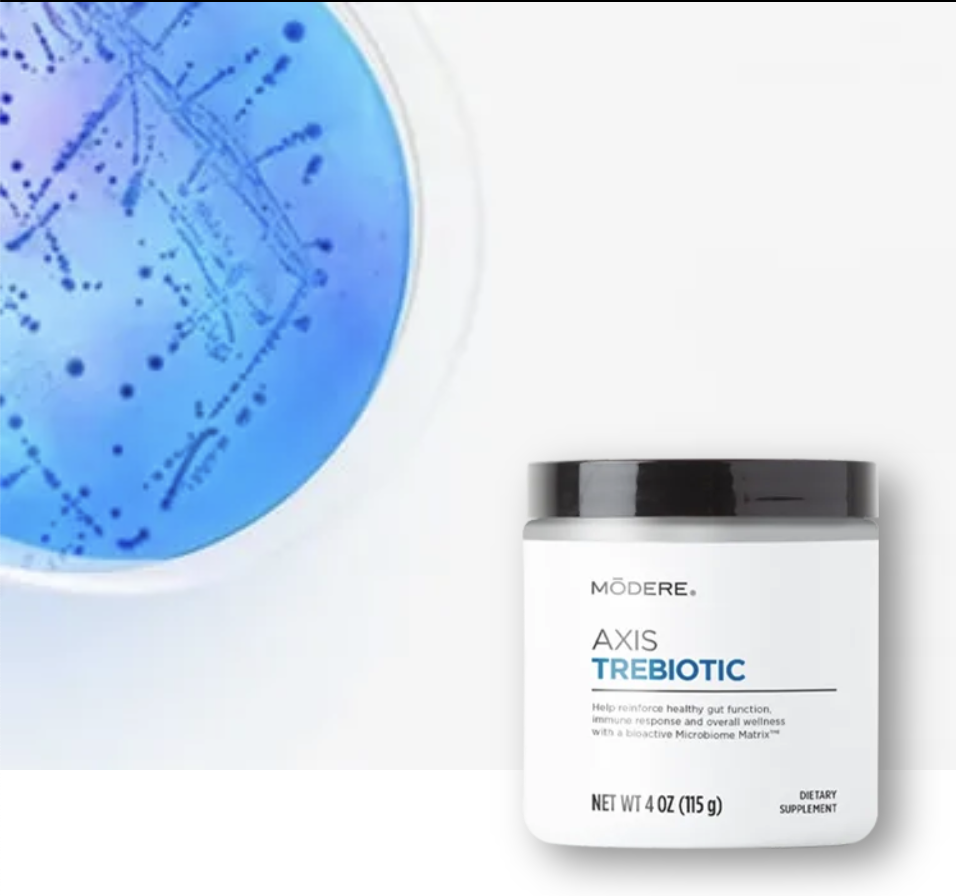
Axis Trebiotics

Wellness For Women.
The journey of wellness began for me 5 years ago after having my 2nd baby. My hormones and gut health were completely out of whack. My mental health + energy were at an all time low. As a mom of 4 I’ve learned that taking care of myself, my hormones, gut health and overall wellness is a priority if I want to be at my best for my family. The products + lifestyle changes I share here I truly believe have made a massive impact on my health and well being.
Click on any Image to go and BUY these products that I am always talking about with your discount!